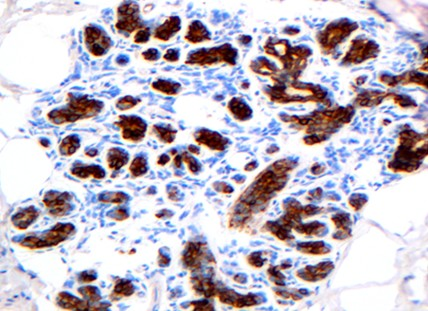

GS环保试剂在病理制片技术工作中的应用
GS环保试剂在病理制片技术工作中的应用
田玉旺 朱红艳 李琳 苗金红 朱培双 邢宜
北京军区总医院病理科
在日常病理组织制片及染色过程中,甲醛和二甲苯作为病理常规试剂被大量应用。这些试剂具有强烈的刺激性和挥发性,不仅污染环境,而且严重危害身体健康。因此,寻找一种对人体******无害且安全的甲醛和二甲苯替代品,已成为病理技术工作者的一种迫切愿望。本文将环保型“GS组织样本制备及染色套液”应用于病理技术工作中,收到了理想制片效果。
1. 材料与方法
1.1 标本
临床送检的各种活体组织病理标本。一组采用传统石蜡制片方法;另组采用环保试剂制片方法,比较二者制片后的各种染色效果。如:HE染色、免疫组化染色及组织化学染色。
1.2 GS环保试剂
GS组织样本制备套液及GS病理切片染色套液(由哈尔滨格林标本技术开发有限公司研制并生产)。
1.3方法
1.3.1 传统石蜡制片法 组织经常规10%中******尔马林固定,酒精脱水,二甲苯透明,石蜡包埋,切片,厚4-5微米。
1.3.2 GS环保试剂制片方法 离体新鲜组织标本经下列步骤处理 = 1 \* GB3 ①固定液 = 1 \* ROMAN I 1h、固定液 = 2 \* ROMAN II 3h; = 2 \* GB3 ②脱水液 = 1 \* ROMAN I×2,分别为40min、1h,脱水液 = 2 \* ROMAN II ×2,分别为30min、1h; = 3 \* GB3 ③透明液 = 1 \* ROMAN I 1h,透明液 = 2 \* ROMAN II 1h30min; = 4 \* GB3 ④浸蜡液 = 1 \* ROMAN I、 = 2 \* ROMAN II各1h30min,石蜡包埋,切片,厚4-5微米。
1.3.3 传统HE染色方法 = 1 \* GB3 ①切片经二甲苯 = 1 \* ROMAN I、 = 2 \* ROMAN II脱蜡各5min; = 2 \* GB3 ②无水酒精、95%酒精、80%酒精各2min,自来水洗; = 3 \* GB3 ③苏木素染8min,自来水洗; = 4 \* GB3 ④1%盐酸酒精分化数秒钟,自来水洗; = 5 \* GB3 ⑤1%氨水返蓝1min,自来水洗; = 6 \* GB3 ⑥1%水溶性伊红染1min; = 7 \* GB3 ⑦70%酒精、95%酒精各10s,无水酒精 = 1 \* ROMAN I、 = 2 \* ROMAN II各2min,二甲苯 = 1 \* ROMAN I、 = 2 \* ROMAN II各2min,中性树胶封片。
1.3.4 GS环保型染液HE染色步骤 = 1 \* GB3 ①切片经脱蜡液 = 1 \* ROMAN I 5min,脱蜡液 = 2 \* ROMAN II 5min,自来水洗2min; = 2 \* GB3 ②苏木素染色液3~5min,自来水洗10s; = 3 \* GB3 ③分化液2~3s,自来水洗1min; = 4 \* GB3 ④蓝化液1min,自来水洗1min; = 5 \* GB3 ⑤伊红染色液1~3min,自来水洗3s; = 6 \* GB3 ⑥除浮染液3s,沥干残余试剂; = 7 \* GB3 ⑦除水透明液1min,沥干; = 8 \* GB3 ⑧透明液3min,无苯封片胶封片。
1.3.5 免疫组织化学染色 乳腺组织采用PV-6000通用二步法分别进行P63和34βE12染色,具体染色步骤同常规。
1.3.6 组织化学染色 胃黏膜组织进行PAS染色,肾组织进行PAMS染色,具体染色步骤同常规。
2. 结果
2.1 采用GS组织样本制备套液制作的组织蜡块,在切片中感觉组织块软硬适中,切片厚薄均匀,连续性好,与传统方法制备的组织蜡块切片效果基本相同。脂肪组织、子宫肌瘤及皮肤等组织切片效果优于传统方法。采用环保型GS染色套液进行HE染色,染液渗透力强,染色速度快,组织结构显示清晰,色彩鲜艳,核浆对比分明,与传统HE染色结果相比二者无明显差异(图1)。
2.2 采用环保型GS组织样本制备套液制作的乳腺组织石蜡切片,经免疫组化P63和34βE12染色,结果显示,细胞内抗原成分保存良好,阳性结果定位准确,背景清晰,与传统方法制片染色效果基本相同(图2,3)。
2.3 GS组织样本制备套液制作的石蜡切片,肾组织进行PAMS染色,胃粘膜组织行PAS组织化学染色,结果显示,肾小球基底膜和胃组织中的中性粘液染色清晰,色泽鲜艳,阳性物质定位准确,与传统方法制片染色效果相同(图4,5)。
3. 讨论
3.1 在组织处理过程中,组织固定至关重要,它直接影响着各种染色效果。采用甲醛固定组织的模式已延续了一百多年。它对组织渗透能力强,组织固定均匀,组织收缩小,尽管它具有高毒性,但由于其成本低,能较好地保存组织结构,所以至今仍广泛被人们所接受。甲醛主要存在以下缺点:①易挥发,具有较强烈的刺激性和腐蚀性[1],严重造成空气和环境污染,而防护又极为困难。国内外医学研究证实,人体皮肤直接接触甲醛时,会引发过敏反应、皮炎或湿疹。长期接触甲醛可能会引发慢性呼吸道疾病、癌症发生,如鼻咽癌、结肠癌、脑瘤、白血病,引起体内白细胞数量下降,导致记忆力和智力下降。2004年6月15日WHO正式宣布甲醛为致癌物质,同时提醒人们要重视甲醛的致癌性,并采取预防措施。②甲醛存放过久易产生白色沉淀即三聚甲醛,而影响组织标本固定效果;③甲醛容易氧化变成甲酸,使溶液变为酸性,导致标本酸化,严重时影响细胞核的染色效果;使用甲醛固定的陈旧组织,以多血的脏器如脾和肝等,组织内易形成甲醛色素,易与含铁血黄素相混淆,使病理诊断受到严重影响;④不能固定肝糖原和尿酸;⑤废液需特殊处理,不能直接排入管道。废液处理费较高,每千克30~40元。 = 6 \* GB3 ⑥目前采用的以醛类为基础的固定液(如甲醛)处理标本,可引起组织内广泛的蛋白质交联,组织切片进行免疫组化染色时因蛋白质交联需进行抗原修复。研究显示,无交联作用的醇类固定剂在保存DNA方面比醛类固定剂效果更好。若单纯用纯酒精固定液或乙醇类固定液,易导致核固缩、细胞空泡出现,组织皱缩,组织变硬变脆等缺陷。理想固定液应该是:毒性低,HE、免疫组织化学及组织化学等染色均可达到******效果,同时还有利于DNA/RNA生物大分子的修复,以便进行分子生物学研究。
3.2 近年来,随着对实验室环境安全更高的要求以及分子生物学飞速发展的需求,研发和生产理想的没有毒性的甲醛替代固定剂已成大势所趋刻不容缓。虽然国外已有使用甲醛、苯类等绿色替代产品进行病理制片的相关报道[2-4],但国内相关报道较少。本文采用的国产GS固定液为环保型无醛复合固定液,它是固定技术的新突破,是病理工作者的福音,它将使建立绿色病理实验室梦想成真。它的特点是无色、无刺激性,低挥发性,不含甲醛等任何醛类化合物,绿色环保,易生物降解,使用后不会对环境产生危害。经大量实际应用,GS固定液与传统甲醛固定液处理的组织制片效果基本相同,它完全可以取代甲醛对组织标本进行固定。它的主要特点 = 1 \* GB3 ①对组织渗透性强,能缩短脱水时间。 = 2 \* GB3 ②能保持良好的组织形态学结构,同时能保护细胞膜的完整性。 = 3 \* GB3 ③有较强的固定、脱水、脱脂兼硬化作用,不易导致组织过度收缩,无细胞空泡与核固缩现象产生。 = 4 \* GB3 ④经GS固定液保存的大体标本,取材时触之感觉良好,易于分离并切取较薄的具有代表性的组织块。可去除脂肪组织标本的粘滑感及粘稠性,使清洁工作快速及简单。尤其对脂肪含量较丰富的组织处理效果更佳。 = 5 \* GB3 ⑤能******限度地保护组织中的抗原和核酸不被破坏、降解或扩散。免疫组化检测结果显示:阳性率和阳性强度与传统制片法效果一致。 = 6 \* GB3 ⑥对DNA和RNA保存较佳,有利于显示细胞的亚结构,对组织标本的分子生物学研究较好,根除了在分子生物学研究中必须使用新鲜组织的必要性。 = 7 \* GB3 ⑦GS固定液回收简便易行,不需甲醛中和剂进行处理废液,可依据乙醇废液处理管理条例处置废液。
3.3 GS脱水液的脱水效果好,不会产生组织脱水过度或脱水不够现象,不易造成组织过度硬化,大小组织可同时进行处理,处理的组织软硬适中,尤其对脂肪、淋巴组织及较坚韧的子宫肌瘤等组织的处理较传统方法制片效果好。
3.4 传统组织处理和染色过程中,二甲苯被病理实验室大量使用,它极易挥发,是一种对人体具有较强毒害作用的有机化学试剂。其毒性主要是对************和植物神经的麻醉及粘膜的刺激作用,长期使用会导致头晕、******、肢体震颤、*********下降等,是致癌物质之一[5]。除对病理工作者的健康构成威胁外,有的单位还将废弃的二甲苯大量的倾倒进下水道也造成了更大范围的城市水系环境污染。在组织处理过程中,若在二甲苯中浸泡时间过长,易产生组织收缩和硬化现象,常使含纤维丰富的组织如子宫肌瘤等组织变得坚硬难切,使含胶质较多的组织变脆后切成条状,使含脂肪较多的组织脱脂不净影响组织浸蜡,导致制片质量下降。
3.5 为了克服二甲苯存在的缺点,有的学者尝试用脱色汽油[6]、硬脂酸[7,8]、异丙醇[9]、松节油等替代二甲苯,虽取得一定效果,但还是存在许多弊端。我们在组织处理和染色中采用了GS环保型脱蜡剂、透明剂和封片剂,收到了理想制片效果。这些试剂均为非苯类******型复合试剂,可以替代二甲苯对组织切片进行脱蜡和染色脱水后的透明处理以及封片,彻底根除了二甲苯对人体的伤害及其对环境的污染。GS脱蜡剂,使组织切片脱蜡彻底,速度快。GS透明剂对组织渗透力强,处理组织软硬适中,对组织处理较温和,组织标本即使较长时间浸泡在其中也不会出现明显的收缩和硬化现象,不易使组织变硬变脆,特别是对子宫肌瘤、皮肤等较韧的含纤维较多的组织柔韧度较好,切片质量好于传统制片法。
3.6 HE染色过程中使用的GS苏木素染色液为无汞染液,对人无危害,对组织亲和力强,染色速度快,不易产生氧化膜而污染组织,切片长期存放细胞核不易褪色,染液使用时间长。镜下组织切片色彩鲜艳,细胞结构清晰,核浆对比分明,与传统HE染色效果一致。
3.7 取材后的组织样本体积在1.5cm×1.5cm×0.3cm范围较好。手术大标本,建议切开后固定,固定剂的量应为标本体积的4~5倍。
针对甲醛和二甲苯的高毒性,国内外学者进行了多年研究,如在甲醛溶液中加入添加剂以减少甲醛的挥发,但效果仍不理想,即使加强通风,并不能完全******其危害。我们使用GS环保试剂替代甲醛及苯类试剂后,从源头上杜绝了有害试剂对室内外环境的污染。GS环保试剂的问世,为建立“绿色实验室”奠定了良好基础,未来的病理实验室将逐步成为环保型的实验室。经大量实际应用证实,环保型GS组织样本制备套液和染色液,完全适用于病理诊断所需的常规HE染色、免疫组化染色及组织化学染色等,其各种染色效果与传统方法制作的切片染色效果相同,值得同行广泛应用。
参考文献
[1] 蒋学之,张瑞稳,王耘兰.甲醛接触人员肿瘤死亡流行病学[J].中华劳动卫生职业病杂志,1990,8:261-264.
[2] Iesurum A,Balbi T,Vasapollo D,et al.Microwave processing and ethanol-based fixation in forensic pathology[J].Am J Forensic Med Pathol,2006,27(127):178-182.
[3] Acton A,Harvey T,Grow M W.An examination of non-formalinbased fixation methods for xenopus embryos[J].Dev Dyn,2005,233(147):1464-1469.
[4] Gillespie JW,Best CJ,Bichsel VE,et al.Evaluation of non-formalin tissue fixation for molecular profiling studies.Am J Pathol,2002,160(127):449-457.
[5] 高蓉梅,彭凤翔,李永春.TO型生物制片透明剂取代二甲苯在病理制片中的应用[J].诊断病理学杂志,2009,12(2):147.
[6] 张穗,程云方,张颜春.脱色汽油代替二甲苯在组织浸蜡前的应用[J].人民军医,1997,40(12):736-737.
[7] 周导,顾萍,严军守.硬脂酸石蜡混合液替代二甲苯透明剂制片的探讨[J].诊断病理学杂志,2006,13(1):75.
[8] 郭以河,张闽峰,孟加榕等..硬脂酸替代二甲苯在组织透明浸蜡过程中的应用[J].实用医技杂志,2008,15(9):1124-1126.
[9] 龙建洲.异丙醇替代二甲苯在组织透明中的应用[J].检验医学与临床,2010,7(2):161-162.

图3乳腺腺病:腺上皮细胞胞浆34βE12(+)。PV-6000法×200

图4 肾组织:肾小球基底膜呈黑色。PAMS×400

图5 胃黏膜组织:中性黏液呈红色。PAS×400
下载地址:

 登陆会员
登陆会员 注册会员
注册会员


 下载中心
下载中心
 病理论坛在线咨询
病理论坛在线咨询